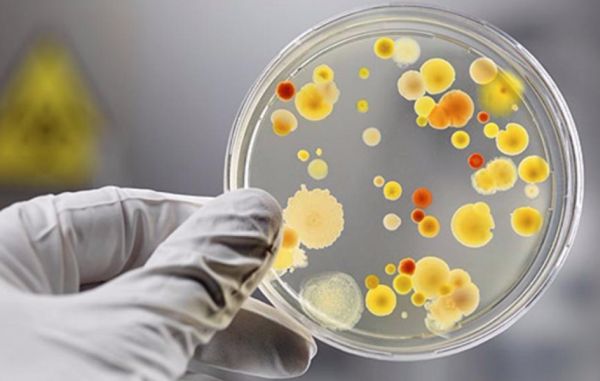

Украине угрожает вирус Коксаки
На турецких курортах, где сейчас отдыхает множество украинцев, произошла вспышка заболевания, вызываемого вирусом Коксаки. Об этом сообщают сами туристы, жертвы вируса. По их свидетельствам, «форма болезни страшная» – сопровождается высокой температурой, сыпью размером с горох по всему телу, обезвоживанием.
Со слов одного из туристов в отеле около тысячи человек, множество детей, треть которых уже переболели или болеют сейчас: «Никто ничего не делает потому что в гостиницах сезон и всем здесь не выгодно что-то делать». Многие отдыхающие собираются прерывать отдых и возвращаться на Украину. За помощью к послу Украины в Турецкой республике и исполняющей обязанности министра здравоохранения Уляне Супрун уже обратились украинские депутаты.
Вспышки заболевания наиболее часто наблюдаются в летний период, при повышенной влажности и в местах большого скопления детей. Турецкие курорты – идеальное место для возникновения эпидемии. Для прекращения распространения вируса в очаге инфекции требуется объявление карантина, изоляция и лечение заболевших, дезинфекция, в особенности воды в бассейнах. Вряд ли в таких мероприятиях заинтересованы владельцы отелей.
Вирус Коксаки не впервые поражает Украину. В прошлом году заболевание фиксировалось на Галичине, где в Тернопольской области в одном из детских садов заболели более 30 детей. Вспышки наблюдались и в Львовской и Ивано-Франковской областях.
Вирус Коксаки относится имеет порядка 30 различных штаммов. Размножается в кишечнике заражённого организма и передаётся через предметы обихода, грязные руки, продукты, воду, либо при кашле и чихании. При близком контакте заболевает до 90% всех контактировавших с больным. Инкубационный период заболевания – от 2 до 10 дней. Преимущественно болеют дети 2-6 лет. После перенесённого заболевания возникает пожизненный иммунитет.
Заболевание может протекать в нескольких формах. Наиболее частая подобна гриппу, с высокой температурой и появлением сыпи. Вторая форма – кишечная, с высокой температурой, рвотой, диареей. У ребёнка может быстро наступить обезвоживание, которое несёт угрозу жизни без адекватного лечения. Третья форма называется Бостонской болезнью, она характеризуется появлением на теле волдырей, напоминающих краснуху и высокой температурой. Четвёртая форма наиболее редкая и тяжёлая – Болезнь Бронхольма. Отмечается высокая температура и резкие боли в грудной клетке и животе, связанные с поражением плевры и брюшины.
Все формы заболевания могут вызвать осложнения в виде миокардита (воспаления сердечной мышцы), менингита (воспаления мозговой оболочки), энцефалита (воспаления мозга), герпетической ангины.
Заболевший нуждается в полноценном жидком питании, большом количестве жидкости, жаропонижающих и противовирусных препаратах. В тяжёлых случаях необходима госпитализация и инфузионная терапия. Как правило, прогноз при данном заболевании благоприятный. Летальные случаи редки и возникают лишь в запущенных формах без адекватной терапии.
Возвращение большого количества заболевших из Турции может вызвать эпидемию заболевания уже на Украине. К этому необходимо серьёзно готовиться, но реформаторы от медицины уничтожили СЭС, закрыли множество лечебных учреждений, да и денег на полноценное лечение у многих людей просто нет. А это означает, что вирус Коксаки получит возможность широко распространиться. Несмотря на множество биологических лабораторий, открытых на Украине за деньги Пентагона с целью «сокращения биологических угроз», говорить об эффективности борьбы с патогенами не приходится: о «страшной форме болезни» украинцы узнают из социальных сетей, в украинских СМИ советуют лечиться от вируса Коксаки «временем» и компенсировать обезвоживание водой, а уж о том, чтобы обследовать прибывающих из Турции украинских туристов и речи нет.
Соб. корр «Одной Родины»













